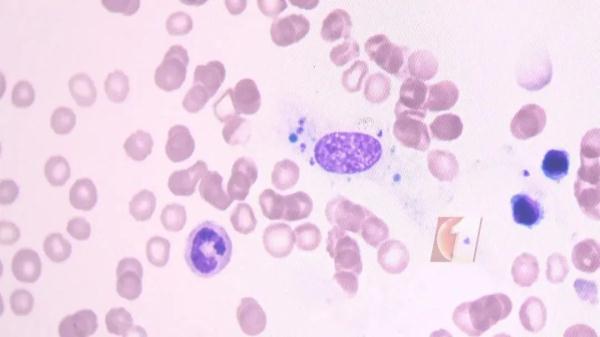

近日
深圳大学总医院
确诊一例罕见的黑热病
该病在我国主要流行区已基本消灭
广东此前也鲜有此类病例的报道
连白血病都查了
最终确诊为黑热病
“刚开始以为是感冒,后来新冠、甲流,甚至连白血病都查了,也查不出病因。”
75岁的陈老伯表示,他上个月到深圳看望儿子时出现发烧症状,抗生素、抗菌药物治疗不见效果,且高烧持续不退,最高烧到39℃。

转入深圳大学总医院后,医生为其进行高通量二代测序(NGS)和骨髓穿刺检查,最终确诊为黑热病。
什么是黑热病?
黑热病是一种由
利什曼原虫感染引起的传染病。
这种病比较罕见,
所以极易误诊、漏诊。
患者如果没有及时治疗,
大多数在1-2年内因并发其他疾病而死亡。

深圳大学总医院检验科主管技师杨礼介绍,黑热病潜伏期一般为3-6个月,主要表现是发烧,还可能有肝脾淋巴结肿大。
如果感染得比较重,有些患者皮肤会变黑,所以称之为黑热病。
幸运的是,患者对症治疗痊愈后,可获得较持久的免疫力,只有极少数免疫力低下的患者可能会再次复发或感染。
据介绍,该病在我国的主要流行区已基本消灭,2019年中国黑热病发病率仅为0.0108/10万。
为什么会感染黑热病?
医生介绍,黑热病的传播媒介是白蛉,白蛉叮咬患有黑热病的病人、病犬以及某些野生动物后,即可感染利什曼原虫。当带虫的白蛉再叮咬人时,人就会被感染。

据陈老伯自述,去年春节到今年年初,他至少到过4个省份:陕西、山东、河南、广东……每到一个地方,基本上都会待1到5个月,探望亲友、旅游、度假。
值得注意的是,去年9、10月期间,他回过老家河南安阳一处太行山脚下的深山中。那里的村子蚊虫出没,他每天出去“遛弯”,每天至少被叮咬十余次。
深圳市疾控中心流调员推断,陈老伯很可能是在老家河南安阳染上了“黑热病”。
因为河南安阳近年来曾报道多例本地黑热病,去年9月,那里的白蛉成虫正好处于“活动季”。而白蛉,正是传播黑热病的“二传手”。
所幸发现及时,经过对症下药,目前陈老伯恢复情况良好。
黑热病没有疫苗可以预防
深圳市疾病预防控制中心传染病预防控制所副所长孔东锋表示,目前黑热病没有疫苗可以预防,所以做好个人防护是很重要的。
白蛉主要在5~9月份进入活跃期,这个期间市民要尽量避免前往白蛉活跃区域或者有黑热病报告地区。
如果一定要去,要做好相应的防护措施,例如在房间使用纱窗和蚊帐、喷洒灭蚊剂等。

白蛉在中国分布很广
医生提醒
白蛉在中国分布很广
主要传播媒介中华白蛉
在长江以北一带活跃
长江以南罕见

当然
只是广东本土风险低
但外来风险还是有的
我国这些地方
都有报告过黑热病
甘肃、四川、陕西、山西
河南、河北、新疆、内蒙古
如果你近期去过这些地方
被白蛉咬过
并且出现持续不断的发热
脾肿大、贫血等症状
记得及时就诊!


点击右上角![]() 微信好友
微信好友
 朋友圈
朋友圈

点击浏览器下方“ ”分享微信好友Safari浏览器请点击“
”分享微信好友Safari浏览器请点击“ ”按钮
”按钮

点击右上角 QQ
QQ

点击浏览器下方“ ”分享QQ好友Safari浏览器请点击“
”分享QQ好友Safari浏览器请点击“ ”按钮
”按钮
